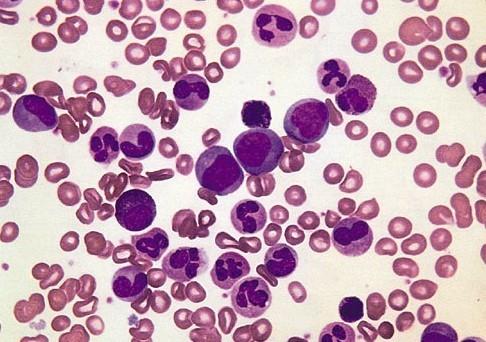
外周血造血干細(xì)胞移植治療地中海貧血

外周血造血干細(xì)胞移植相對(duì)于骨髓造血干細(xì)胞移植的優(yōu)點(diǎn)在于能夠使患者獲得更穩(wěn)定的移植物體系�,并且細(xì)胞收集相對(duì)容易,在移植前通常注射造血細(xì)胞生長(zhǎng)因子促使骨髓中的干細(xì)胞釋放到外周血中�����,并采用血細(xì)胞單采技術(shù)獲取供者外周血造血干細(xì)胞���。與需要進(jìn)行手術(shù)的骨髓捐獻(xiàn)方式相比���,捐贈(zèng)者更愿意選擇無創(chuàng)傷性的外周血造血干細(xì)胞捐贈(zèng)方式,所以許多國(guó)家的研究主要是以非親緣捐贈(zèng)者的外周血造血干細(xì)胞為細(xì)胞來源進(jìn)行治療,由于非親緣外周血造血干細(xì)胞移植會(huì)增加術(shù)后移植物抗宿主病風(fēng)險(xiǎn)和移植相關(guān)病死率�����,故目前僅用于兒童地中海貧血治療�����。
使用一種新型移植方案(通過靜脈注射白消安��、環(huán)磷酰胺��、氟達(dá)拉濱和噻替派進(jìn)行藥物預(yù)處理)治療82例地中海貧血患者����,其中52例人類白細(xì)胞抗原配型通過者用非親緣外周血造血干細(xì)胞移植治療,30例進(jìn)行人類白細(xì)胞抗原相合同胞外周血造血干細(xì)胞移植治療���,移植對(duì)象的年齡范圍在0.6-15歲(中位年齡為6歲)����,男女比例56:26�����,隨訪12-39個(gè)月。
結(jié)果表明:
非親緣外周血造血干細(xì)胞移植組3年總生存率和無地中海貧血生存率分別為92.3%和90.4%�,人類白細(xì)胞抗原相合同胞外周血造血干細(xì)胞移植組分別為90.0%和83.3%;
非親緣外周血造血干細(xì)胞移植組累計(jì)移植物排斥發(fā)生率和Ⅲ-Ⅳ級(jí)急性移植物抗宿主病的發(fā)生率分別為1.9%和9.6%�����,人類白細(xì)胞抗原相合同胞外周血造血干細(xì)胞移植組分別為6.9%和3.6%����;
非親緣外周血造血干細(xì)胞移植組移植相關(guān)病死率為7.7%,人類白細(xì)胞抗原同胞外周血造血干細(xì)胞移植組為10.0%���。
該結(jié)果表明經(jīng)新型方案處理后的非親緣外周血造血干細(xì)胞移植與人類白細(xì)胞抗原相合同胞外周血造血干細(xì)胞移植結(jié)果相似,在臨床治療中如果缺乏匹配供者來源�,可選擇非親緣外周血造血干細(xì)胞移植治療β地中海貧血。